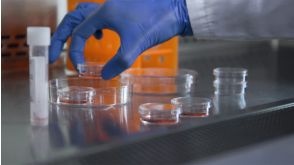
CFU Assay Instructions for Global Proficiency Testing Programs

视频和线上讲座
Featured
Human Primary Cells - Get the Cells You Need from STEMCELL Technologies
Learn how you can reduce experimental uncertainty and increase confidence in your results by choosing STEMCELL Technologies as your dependable supplier of quality human primary cells that consistently meet your requirements.
Publish Date: December 01, 2023

EasySep™小鼠TIL(CD45)正选试剂盒

沪公网安备31010102008431号